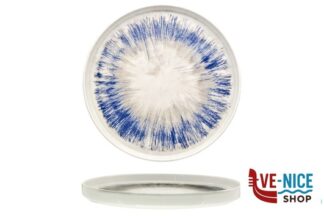
piano FREEDOM BLU OSLO - PIATTO PIANO NORDIC CM 28 SATURNIA

piano
Visualizzazione di 49-72 di 219 risultati
-

piano ECLIPSE-PIATTO PIANO CM 25 A FALDA- ALLUMINA ARIANE FINE PORCELAIN
8,45 € Aggiungi al carrello Confronta -

piano ECLIPSE-PIATTO PIANO CM 27 A FALDA- ALLUMINA ARIANE FINE PORCELAIN
10,73 € Aggiungi al carrello Confronta -

piano ECLIPSE-PIATTO PIANO CM 29 A FALDA- ALLUMINA ARIANE FINE PORCELAIN
13,70 € Aggiungi al carrello Confronta -

piano FREEDOM BLU KIMI – PIATTO RETTANGOLARE CM 26X15 SATURNIA
8,43 € Aggiungi al carrello Confronta -

piano FREEDOM BLU KIMI – PIATTO RETTANGOLARE CM 29X17,5 SATURNIA
9,65 € Aggiungi al carrello Confronta -

piano FREEDOM BLU NAPOLI – PIATTO PORTATA KONOS CM 28 SATURNIA
7,28 € Aggiungi al carrello Confronta -

piano FREEDOM BLU OSLO – PIATTO PIANO NORDIC CM 20 SATURNIA
6,75 € Aggiungi al carrello Confronta -

piano FREEDOM BLU OSLO – PIATTO PIANO NORDIC CM 28 SATURNIA
9,21 € Aggiungi al carrello Confronta -

piano FREEDOM BLU SIVIGLIA – PIATTO FRUTTA CM 21 SATURNIA
4,24 € Aggiungi al carrello Confronta -

piano FREEDOM BLU SIVIGLIA – PIATTO PIANO CM 26 SATURNIA
4,37 € Aggiungi al carrello Confronta -

piano FREEDOM BLU SIVIGLIA – PIATTO PIANO CM 28 SATURNIA
5,33 € Aggiungi al carrello Confronta -

piano FREEDOM BLU SIVIGLIA – PIATTO PORTATA CM 31 SATURNIA
8,48 € Aggiungi al carrello Confronta -

piano FROSTY DEM – PIATTO PIANO 25 P DEM
1,77 € Aggiungi al carrello Confronta -

piano GALAXIA-PIATTO PIANO CM 20,5 BOSS IN STONEWARE ZAKLADY PORCELANY STOLOWEJ LUBIANA
5,46 € Aggiungi al carrello Confronta -

piano GALAXIA-PIATTO PIANO CM 27 BOSS IN STONEWARE ZAKLADY PORCELANY STOLOWEJ LUBIANA
5,79 € Aggiungi al carrello Confronta -

piano GALAXIA-PIATTO PIANO CM 31 BOSS IN STONEWARE ZAKLADY PORCELANY STOLOWEJ LUBIANA
13,83 € Aggiungi al carrello Confronta -

piano GALAXIA-PIATTO RETTANGOLARE CM 29X13 SAN MARINO IN STONEWARE ZAKLADY PORCELANY STOLOWEJ LUBIANA
12,00 € Aggiungi al carrello Confronta -

piano GALAXIA-PIATTO RETTANGOLARE CM 31X24 SAN MARINO IN STONEWARE ZAKLADY PORCELANY STOLOWEJ LUBIANA
14,69 € Aggiungi al carrello Confronta -

piano GIOTTO BIANCO – PIATTO OVALE CM 29 SATURNIA
8,73 € Aggiungi al carrello Confronta -

piano GIOTTO BIANCO – PIATTO OVALE CM 34 SATURNIA
13,94 € Aggiungi al carrello Confronta -

piano GIOTTO BIANCO – PIATTO PASTA CM 28 SATURNIA
6,55 € Aggiungi al carrello Confronta -

piano GIOTTO BIANCO – PIATTO PIANO CM 18 SATURNIA
4,41 € Aggiungi al carrello Confronta -

piano GIOTTO BIANCO – PIATTO PIANO CM 21 SATURNIA
4,60 € Aggiungi al carrello Confronta -

piano GIOTTO BIANCO – PIATTO PIANO CM 28 SATURNIA
4,97 € Aggiungi al carrello Confronta
Visualizzazione di 49-72 di 219 risultati